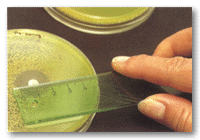

|
The effects
of antibiotics on bacteria count |
|
|
|
Introduction:
Since the middle of this
century, antibiotics have been used very successfully to fight
against infections. The first of them was penicillin, discovered
by Alexander Fleming in 1928. This antibiotic is produced by the
fungus Penicillium notatum. The role of an antibacterial
therapy is to support the functions of the body's immune system by
killing the bacterial pathogens (bactericidal effect), or at least
preventing the pathogen multiplication (bacteriostatic effect). |
|
|
|
|
Project
description:
In this project you will study the effect of antibiotics on bacteria
count. You will need to repeat a bacteria growth experiment without and
with different amounts of antibiotics. |
Details
of this project:
More details or support for this project is available for the
members of ScienceProject.com web site. Material
needed for experiment or a science kit about this title may be
available at MiniScience.com. |
|
|
|
|
|
|
|
|